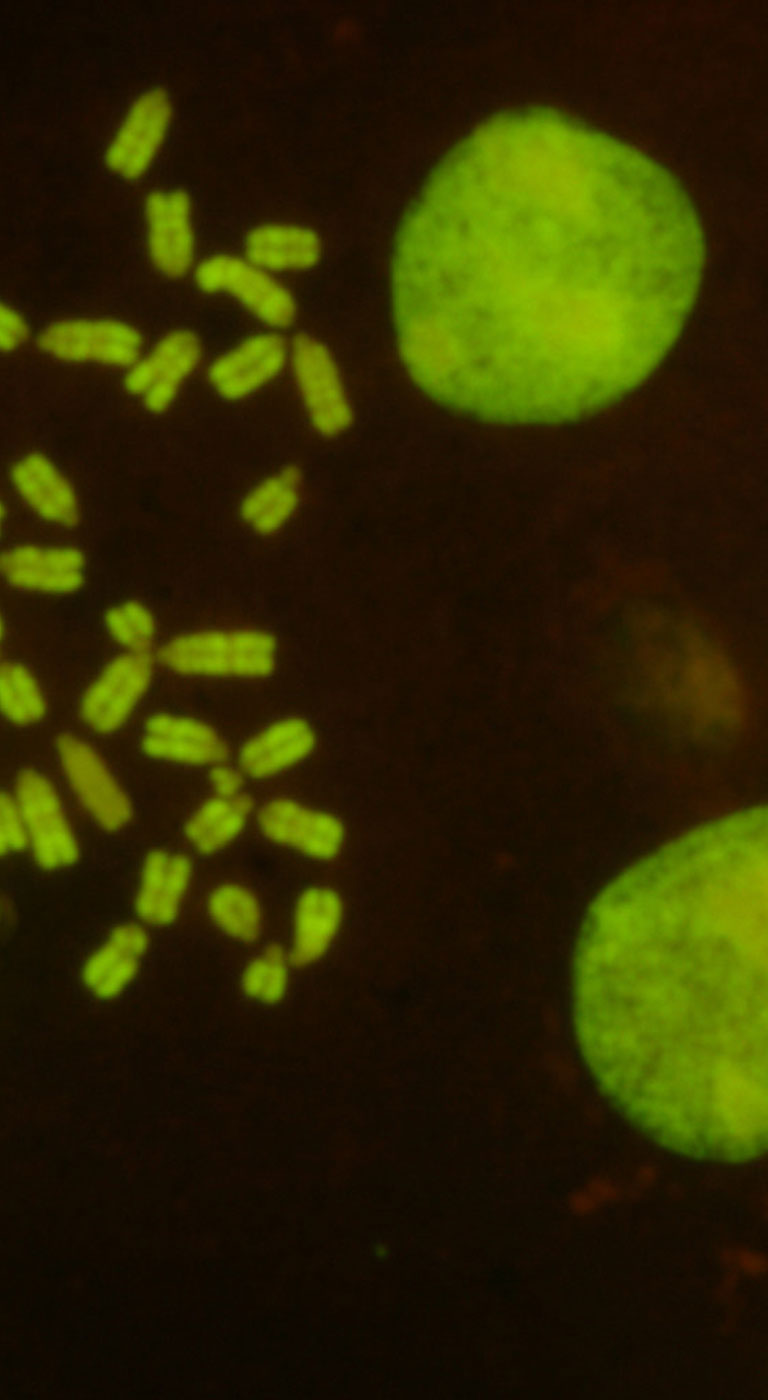

We are more than the sum of our genes.
PICK UP
Newsお知らせ
- 2026.01.21
- お知らせ2026年 日本エピジェネティクス研究会奨励賞募集のお知らせ
- 2026.01.21
- 求人募集群馬大学 生体調節研究所(服部研究室)准教授または講師の募集のお知らせ
- 2026.01.20
- お知らせ2026年第19回年会 HP公開のお知らせ
- 2026.01.08
- イベントCold Spring Harbor Asia Meeting on Chromatin, Epigenetics & Transcription開催のお知らせ
- 2025.12.24
- お知らせエピジェネティクス研究会ウェビナーシリーズ 第三回開催のご案内
日本エピジェネティクス研究会事務局
〒260-8670 千葉市中央区亥鼻1-8-1
千葉大学大学院医学研究院分子腫瘍学内
庶務担当幹事:金田篤志、担当:江島加余子
Tel: 043-226-2039
E-mail: jse-jimukyoku@ml.chiba-u.jp

トミーデジタルバイオロジー
メルク株式会社
アクティブ・モティフ株式会社
ノボジーン株式会社
株式会社Rhelixa
